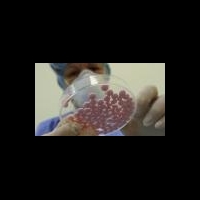

Уважаемые коллеги! Приглашаем Вас и Ваших коллег принять участие в 4-й
В НИИ СП им. Н.В. Склифосовского провели пересадку легких пациентке с муковисцидозом. Программа трансплантации легких, успешно стартовавшая в НИИ СП им. Н.В. Склифосовского в прошлом году, п
Watch the INTRABEAM IORT Procedure for Breast Cancer
найти-врача.рф это рекомендательный сервис по выбору врача и медучреждений, первый в России.
Выберите свой город, например, Москва.
На сайте необходимый специалист ответит на Ваш вопрос онлайн, даст совет и осуществит запись на прием для проведения консультации, так же можете узнать возможен ли вызов на дом. После того как врач проведет осмотр, либо вы посетите медучреждения из каталога найти-врача.рф, обязательно оставьте свои отзывы, помогите сделать выбор другим.
Вы можете найти адреса и телефоны интересующих Вас медучреждений.
Поиск врача и мед учреждения - большая и ответственная работа, в которой найти-врача.рф станет Вашим первым помощником.
Врач же может найти на сайте найти-врача.рф признание пациентов и список вакансий.
Новости
Фонды РВК вложили в проекты по биотеху и медицине около 2,5 млрд руб
Венчурные фонды, созданные при участии ОАО "Российская венчурная компания" (РВК), к настоящему времени инвестировали в проекты по биотехнологиям и медицинской технике около 2,5 миллиарда рублей, сообщил в понедельник глава РВК Игорь Агамирзян.
Выступая на втором международном форуме "Исследование и разработка инновационных препаратов в России", Агамирзян отметил, что биомедицина является одним из приоритетных направлений работы фондов РВК.
По его словам, общий объем инвестиций всех венчурных фондов с участием РВК составляет примерно 8,5 миллиарда рублей.
Форум "Исследование и разработка инновационных препаратов в России" организован Институтом Адама Смита (Adam Smith Conferences, Великобритания).
ОАО "Российская венчурная компания" - государственный фонд фондов и институт развития РФ, один из ключевых инструментов государства в деле построения национальной инновационной системы.
Источник: http://ria.ru
Есть мысли на тему новости? Поделитесь!
Другие новости
Британские врачи пришли к заключению о различиях в течении острых респираторных заболеваний у мужчин и женщин
Первые диагностические центры женского здоровья уже открыты в Санкт-Петербурге и Владивостоке, по инициативе С.В.Медведевой
Американские ученые сообщили об успешной трансплантации клеток сетчатки. Экспериментальное исследование на мышах с поврежденными генами
Исследователи из Нидерландской королевской академии наук изучили процессы запоминания и обучения у взрослых людей
Препарат против катаракты на основе "ионов Скулачева" вступил в следующую фазу клинических испытаний. Планируемый выход в продажу в 2012 году